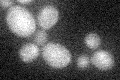
YDR350C
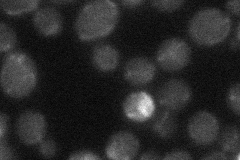
YDR350C

View description
Mitochondrial inner membrane protein required for assembly of the F0 sector of mitochondrial F1F0 ATP synthase, which is a large, evolutionarily conserved enzyme complex required for ATP synthesis
Localization:
Intensity:
Fold change:
Significance:
-
C’ GFP library in SD
below threshold18.86 -
N' NOP1pr-GFP in SD

mitochondria44.4238 -
N' TEF2pr-mCherry in SD

punctate,mitochondria21.2007 -
N' NATIVEpr-GFP in SD
mitochondria18.6968 -
N' TEF2pr-VC and Cyto-VN in SD

#N/A0 -
C’ GFP library in SD+DTT

cytosol13.080.69No -
C’ GFP library in SD+H2O2

cytosol16.450.87No -
C’ GFP library in Starvation Media

cytosol14.70.77No -
C’ GFP library on the background of Pup2-DaMP

below threshold -
C’ GFP library on the background of CCT mutant

below thresholdN/AN/ANo
